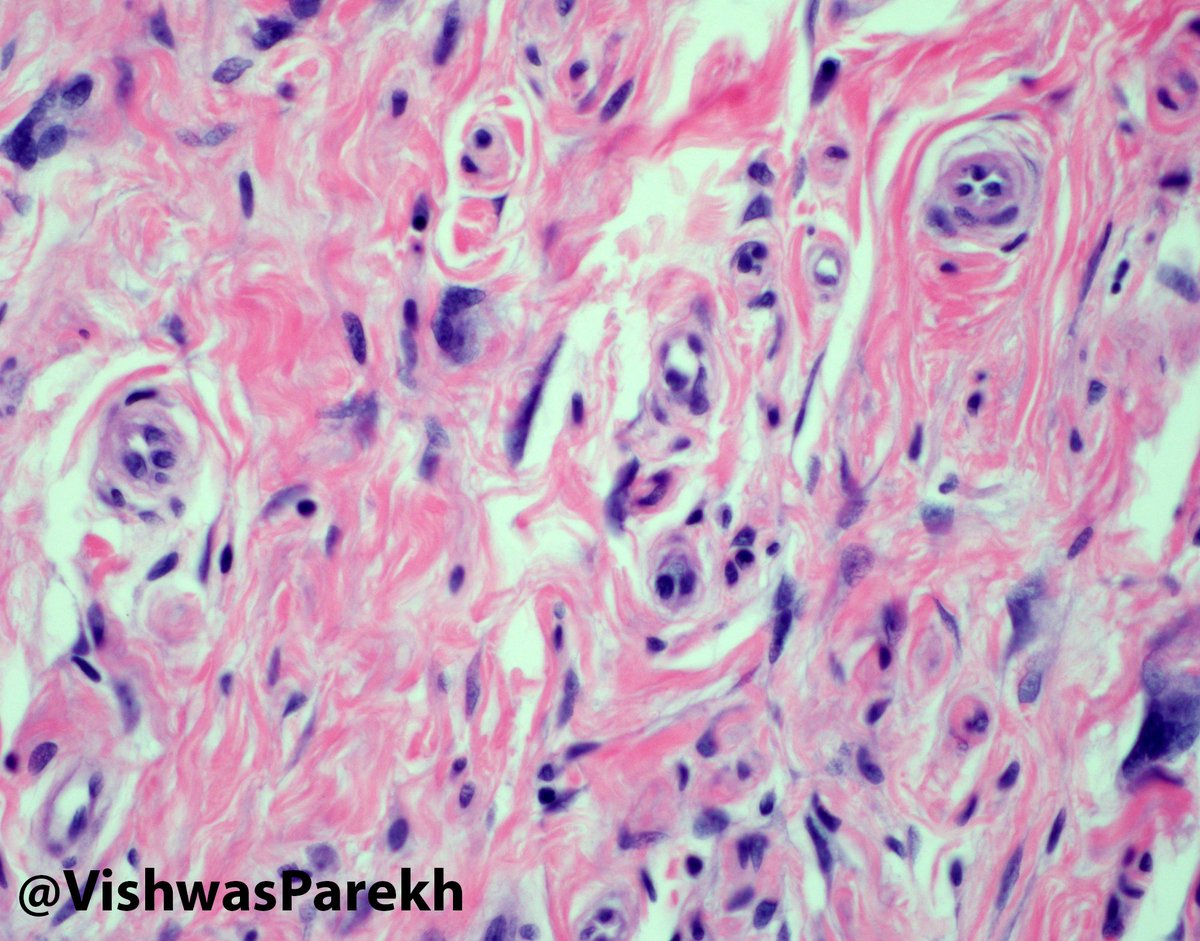
Multinucleate Cell Angiohistiocytoma—angulated multinucleate cells, numerous capillaries, F13a+ #Dermpath #Pathology

Vishwas Parekh, MD
@vishwasparekh
Assistant clinical professor of Pathology @cityofhope | Dermatopathologist | Pathologist | Medical director IHC laboratory | Editor @ArchivesPath | No PHI
ID: 3422423915
14-08-2015 15:57:54
334 Tweet
2,2K Followers
776 Following
















QA in Breast Pathology: Lessons Learned From a Review of Amended Reports, current Arch Pathol Lab Med: capatholo.gy/2kaQ2gp #pathologists


@CArnold_GI @jachavez23 Sean R Williamson MD Rashna Meunier, MD Frank Ingram, MD Xiaoyin "Sara" Jiang, MD (She/Her) I call it Vish's Snake Pit. Also cool band name😜 Vishwas Parekh, MD